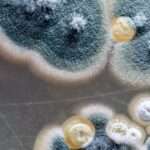
Mohos domésticos

Las varices en las extremidades inferiores son un trastorno común que se desarrolla cuando las venas superficiales se dilatan, retuercen y agrandan, lo que genera un aspecto de «cuerdas» o «lianas» visibles bajo la piel. Este fenómeno tiene su origen en la incapacidad de las válvulas venosas para cerrar adecuadamente, lo que permite el flujo retrógrado de sangre y genera un aumento de la presión venosa, fenómeno que se denomina hipertensión venosa. Aunque diversos factores pueden contribuir al desarrollo de las varices, las condiciones de alta presión venosa, especialmente aquellas asociadas con períodos prolongados de pie o con esfuerzos intensos, como el levantamiento de pesas, son factores predisponentes importantes. Sin embargo, la mayor incidencia de varices se observa en las mujeres, particularmente después del embarazo, lo que sugiere que los factores hormonales y mecánicos desempeñan un papel crucial en su desarrollo.
El embarazo induce una serie de cambios fisiológicos que favorecen la aparición de varices. Durante el embarazo, el aumento del volumen sanguíneo, las alteraciones hormonales (especialmente el aumento de la progesterona, que reduce el tono muscular venoso) y el aumento de la presión intraabdominal debido al crecimiento del útero afectan directamente la circulación venosa de las extremidades inferiores. Esto provoca una sobrecarga en el sistema venoso superficial, particularmente en las venas de las piernas, y en consecuencia, una mayor susceptibilidad a la dilatación venosa. Además, en las mujeres, la predisposición genética también juega un papel fundamental, dado que se ha observado que el riesgo de desarrollar varices es más alto en aquellas que tienen antecedentes familiares de esta afección.
La enfermedad venosa crónica es una condición que se caracteriza por una combinación de reflujo venoso progresivo y hipertensión venosa. El reflujo venoso ocurre cuando las válvulas dentro de las venas superficiales, que normalmente permiten que la sangre fluya en una sola dirección hacia el corazón, no funcionan correctamente. Como resultado, la sangre se acumula en las venas de las extremidades inferiores, lo que aumenta la presión venosa y contribuye a la dilatación de las venas. Las venas más comúnmente afectadas son la gran vena safena y sus ramas tributarias, que son las principales venas superficiales de las piernas, aunque la pequeña vena safena, ubicada en la parte posterior de la pierna, también puede verse involucrada. La distensión de estas venas dificulta el funcionamiento normal de las válvulas, que se separan y no pueden coaptarse adecuadamente, lo que impide el retorno adecuado de la sangre hacia el corazón y provoca el reflujo sanguíneo hacia los pies.
En algunos casos, las varices pueden ser secundarias a otras condiciones, como la tromboflebitis (inflamación de una vena debido a la presencia de un coágulo sanguíneo) o cambios obstructivos en el sistema venoso profundo. En estas situaciones, las venas profundas pueden sufrir daño a nivel de las válvulas o pueden verse obstruidas por trombos, lo que aumenta la presión venosa en el sistema superficial y lleva a la formación de varices. De manera más rara, las varices pueden ser el resultado de una obstrucción venosa proximal debida a la presencia de tumores (neoplasias) o fibrosis en los grandes vasos venosos, lo que dificulta el flujo sanguíneo adecuado y aumenta la presión en las venas periféricas.
Además, en algunos pacientes jóvenes, las varices pueden estar asociadas con malformaciones arteriovenosas congénitas o adquiridas, así como con fístulas arteriovenosas, que son conexiones anormales entre arterias y venas. Estas condiciones pueden alterar significativamente el flujo sanguíneo en las venas y promover la dilatación venosa, lo que resulta en varices. Por ello, en pacientes jóvenes que presentan varices, es esencial considerar la posibilidad de estas malformaciones vasculares.
Manifestaciones clínicas
La severidad de los síntomas en las varices no guarda una relación directa con el número o el tamaño de las varicosidades, lo que significa que una persona con una gran cantidad de venas varicosas o venas de gran tamaño puede no experimentar síntomas subjetivos importantes, mientras que una persona con varices menos extensas o de menor tamaño puede sentir una intensidad de síntomas considerable. Este fenómeno resalta la complejidad de la enfermedad venosa crónica, ya que la presencia de varices no siempre se correlaciona con la intensidad de las molestias que experimenta el paciente.
Uno de los síntomas más comunes asociados con las varices es una sensación de pesadez o cansancio en las piernas, que tiende a empeorar con los períodos prolongados de pie o con la permanencia en posiciones verticales. Esta pesadez se debe principalmente a la acumulación de sangre en las venas dilatadas, lo que aumenta la presión venosa y dificulta el retorno de la sangre hacia el corazón, provocando una sensación de fatiga y malestar. La sensación de pesadez se asocia a menudo con un dolor sordo y difuso en las piernas, que se alivia al elevar las extremidades o al caminar, lo que favorece el retorno venoso.
Además de la pesadez, la piel de la zona afectada puede presentar síntomas adicionales, como picazón. El picor en la piel se debe a la eccema venoso, una condición que puede desarrollarse en la piel que recubre las varices. Esta dermatitis venosa es comúnmente observada por encima de los tobillos, o directamente sobre las varices de gran tamaño, y puede acompañarse de enrojecimiento, inflamación e irritación. El eccema venoso es resultado de la acumulación de productos de desecho y una deficiente oxigenación de los tejidos debido a la hipertensión venosa crónica.
En casos más avanzados, las varices se hacen más evidentes. Las venas dilatadas y tortuosas, tanto en el muslo como en la pantorrilla, son visibles y palpables cuando el paciente se encuentra de pie. Esta visibilidad aumenta a medida que las venas se dilatan y se vuelven más tortuosas, lo que refleja la insuficiencia en el sistema venoso superficial. No obstante, la apariencia externa de estas venas no siempre es indicativa de la severidad de los síntomas que el paciente experimenta.
Si las varices persisten y no se tratan adecuadamente, pueden evolucionar hacia una insuficiencia venosa crónica. En este estadio, la insuficiencia venosa provoca una serie de complicaciones adicionales. Uno de los signos más frecuentes es el edema o hinchazón en los tobillos, que ocurre debido a la acumulación de líquido en los tejidos periféricos, como resultado de la incapacidad de las venas para manejar adecuadamente la presión. Esta acumulación de fluido también puede dar lugar a una hiperpigmentación cutánea de tono marrón, particularmente en la región alrededor de los tobillos, debido a la extravasación de hemoglobina descompuesta de los glóbulos rojos que se acumulan en los tejidos. A medida que la condición progresa, puede producirse una induración o fibrosis de la piel, lo que significa que la piel se vuelve más gruesa y menos elástica debido a los cambios en el tejido subcutáneo.
En cuanto a los signos clínicos, es importante destacar que las varices primarias nunca producen un bruit o thrill (ruido o vibración palpable), que son características de las lesiones vasculares arteriovenosas. La presencia de un ruido o vibración sobre una variz sugiere la existencia de una fístula arteriovenosa o una malformación arteriovenosa, que son condiciones raras en las que una arteria y una vena se conectan de forma anormal, lo que provoca un flujo sanguíneo turbulento y puede ser percibido como un sonido o una vibración sobre la piel. Estas malformaciones requieren una evaluación y un tratamiento específicos, ya que no están relacionadas con las varices primarias y tienen un manejo distinto.
Exámenes complementarios
La identificación de la fuente del reflujo venoso que alimenta las venas sintomáticas es fundamental para un tratamiento quirúrgico eficaz, ya que conocer con precisión el origen del reflujo permite al cirujano dirigir de manera específica la intervención, maximizando así los beneficios y minimizando posibles complicaciones. En el contexto de la enfermedad venosa crónica, el reflujo venoso se produce cuando las válvulas dentro de las venas no funcionan adecuadamente, lo que permite que la sangre fluya en dirección contraria, acumulándose en las venas superficiales de las extremidades inferiores. Esto no solo empeora los síntomas del paciente, como la sensación de pesadez, dolor o fatiga, sino que también puede contribuir a la progresión de la insuficiencia venosa crónica con complicaciones como edema, hiperpigmentación y fibrosis cutánea.
El reflujo venoso puede originarse en distintas partes del sistema venoso, y la identificación precisa de la vena o las venas responsables de este reflujo es esencial para la planificación del tratamiento quirúrgico. Si bien existen varias venas en las extremidades inferiores que pueden verse afectadas por reflujo venoso, la gran vena safena es la fuente más común de reflujo en la mayoría de los casos. La gran vena safena, que se extiende desde el pie hasta la ingle, conecta con las venas perforantes y otras venas superficiales, y cuando presenta insuficiencia de válvulas, el reflujo sanguíneo hacia las venas más pequeñas de la pierna puede causar la aparición de varices.
Para poder realizar un tratamiento quirúrgico adecuado, es imprescindible localizar con precisión el punto exacto en el que se origina el reflujo, ya que esto permite al cirujano decidir qué tipo de intervención realizar, ya sea una cirugía de ligadura y stripping (eliminación de la vena afectada), una esclerosis endovenosa o una ablación térmica. La intervención se realiza con el objetivo de cerrar o eliminar la vena que está permitiendo el reflujo, restableciendo así la circulación venosa normal en las extremidades inferiores.
El examen diagnóstico de elección para la localización del reflujo venoso es la ecografía duplex (ultrasonografía dúplex), que es una técnica no invasiva que combina la ultrasonografía tradicional con el Doppler, permitiendo visualizar las venas y evaluar el flujo sanguíneo en tiempo real. Este examen proporciona información detallada sobre el tamaño de las venas afectadas, la presencia de reflujo y el punto específico en el que se origina el problema, lo que lo convierte en una herramienta fundamental para el diagnóstico y la planificación terapéutica. Para obtener resultados precisos, es crucial que la ecografía duplex sea realizada por un técnico con experiencia en la evaluación y localización del reflujo venoso, ya que la correcta interpretación de las imágenes y la identificación del punto de inicio del reflujo son determinantes para la elección del tratamiento más adecuado.
La ecografía duplex permite a los especialistas evaluar la anatomía venosa en su totalidad, identificar las venas superficiales y profundas involucradas y determinar el grado de insuficiencia venosa. Al identificar la gran vena safenacomo la fuente principal del reflujo, se puede determinar si es necesario realizar una intervención en esta vena o si otras venas accesorias están involucradas. Además, la ecografía duplex también ayuda a evaluar la eficacia de los tratamientos previos, como la esclerosis o la cirugía, al permitir el seguimiento de la resolución del reflujo después de la intervención.
Diagnóstico diferencial
La diferenciación entre las varices causadas por un reflujo venoso superficial primario y aquellas secundarias a una obstrucción previa o en curso de las venas profundas, como en el síndrome postrombótico, es crucial para un diagnóstico y tratamiento adecuados. Las varices primarias, que son el resultado de una insuficiencia funcional de las válvulas venosas en el sistema venoso superficial, se caracterizan por la dilatación y tortuosidad de las venas superficiales sin que exista una obstrucción significativa en el sistema venoso profundo. Este tipo de varices suele ser más frecuente en pacientes con predisposición genética, y generalmente se asocia con factores como el embarazo, la posición prolongada de pie o el envejecimiento.
Sin embargo, cuando las varices son secundarias a una obstrucción de las venas profundas, como es el caso en el síndrome postrombótico, la patología es más compleja. En estos casos, la obstrucción de las venas profundas, que generalmente es resultado de una trombosis venosa profunda previa (un coágulo sanguíneo que bloquea el flujo venoso en las venas profundas), conduce a una alteración en el drenaje venoso normal. La obstrucción en las venas profundas provoca un aumento de la presión venosa en las venas superficiales, lo que puede dar lugar a la aparición de varices como un mecanismo compensatorio para el retorno de sangre hacia el corazón. Las varices secundarias a esta obstrucción pueden presentar síntomas más graves, como edema persistente, hiperpigmentación de la piel y en algunos casos, úlceras venosas.
Por tanto, es fundamental que los clínicos sean capaces de diferenciar las varices primarias de las secundarias, ya que el tratamiento de ambas condiciones varía considerablemente. Mientras que las varices primarias suelen tratarse mediante procedimientos que aborden el reflujo venoso superficial, como la eliminación o la ablación de la vena safena, las varices secundarias pueden requerir una evaluación más extensa del sistema venoso profundo, y en algunos casos, el tratamiento de la trombosis venosa profunda subyacente. Además, la presencia de varices secundarias a una obstrucción venosa profunda puede ser un indicador de insuficiencia venosa crónica, lo que requiere un enfoque terapéutico más completo y a largo plazo.
Otra distinción importante en los pacientes con varices es la necesidad de diferenciar entre el dolor o malestar causado por neuropatía y aquellos síntomas directamente relacionados con las varices. La neuropatía, que implica una alteración en los nervios periféricos, puede causar dolor, ardor, hormigueo o entumecimiento en las extremidades, y en ocasiones se puede confundir con los síntomas de las varices, que suelen incluir dolor sordo, pesadez y calambres. Dado que los tratamientos para estas condiciones son muy diferentes, es esencial realizar una evaluación exhaustiva para identificar la causa del malestar. Mientras que las varices se asocian con un aumento de la presión venosa y un flujo sanguíneo inadecuado, la neuropatía se trata generalmente con intervenciones que aborden el sistema nervioso, como medicamentos o terapia física.
Del mismo modo, el dolor en las piernas relacionado con las varices debe ser diferenciado del dolor debido a claudicación intermitente, una condición comúnmente asociada con la obstrucción arterial. La claudicación intermitente se caracteriza por dolor muscular en las piernas que aparece después de una cantidad predecible de ejercicio y se resuelve con el reposo. Este tipo de dolor es el resultado de la falta de flujo sanguíneo adecuado hacia los músculos durante la actividad física debido a la presencia de una obstrucción arterial. A diferencia del dolor causado por varices, que está relacionado con la presión venosa elevada, el dolor de la claudicación intermitente mejora con el reposo, ya que al detenerse la actividad física, el flujo sanguíneo hacia los músculos se restablece.
En los pacientes adolescentes que presentan varices, la evaluación diagnóstica debe ser aún más rigurosa. En este grupo etario, las varices pueden ser indicativas de una malformación congénita o atresia del sistema venoso profundo, condiciones que son relativamente raras, pero que pueden alterar significativamente la circulación venosa en las extremidades. La atresia venosa se refiere a una malformación en la que una o más venas profundas no se desarrollan adecuadamente, lo que puede llevar a un drenaje venoso insuficiente y una dependencia excesiva de las venas superficiales para el retorno venoso. En estos casos, realizar un tratamiento quirúrgico de las varices, como la extirpación o ablación de la gran vena safena, puede ser contraproducente, ya que las venas superficiales pueden estar jugando un papel crucial en el drenaje de la extremidad afectada.
Por lo tanto, en pacientes jóvenes con varices, es obligatorio realizar una imagenología detallada del sistema venoso profundo, como la ecografía duplex o la flebografía, para descartar malformaciones congénitas o atresias de las venas profundas. Si se confirma que las venas superficiales están desempeñando un papel esencial en la circulación venosa del miembro, la intervención quirúrgica debe evitarse, ya que eliminar o tratar estas venas podría comprometer aún más el drenaje venoso y provocar complicaciones graves, como el desarrollo de úlceras o insuficiencia venosa crónica.
Complicaciones
La tromboflebitis superficial de las varices es una condición relativamente infrecuente, aunque puede presentarse ocasionalmente en pacientes con venas varicosas. Esta afección se caracteriza por la formación de un coágulo sanguíneo en una vena superficial dilatada, lo que desencadena una respuesta inflamatoria local. La presentación típica de la tromboflebitis superficial en las varices es la aparición repentina de dolor localizado en la zona afectada, acompañado de venas sensibles al tacto, que se sienten firmes al palparlas debido a la presencia del trombo dentro de la vena. Aunque la tromboflebitis superficial puede ser dolorosa e incómoda, el proceso suele ser autolimitado, lo que significa que tiende a resolverse de forma espontánea en un período de varias semanas, con una resolución gradual de la inflamación y el dolor a medida que el cuerpo resuelve el coágulo.
Es importante señalar que la tromboflebitis superficial de las varices presenta un riesgo muy bajo de complicaciones graves, como la trombosis venosa profunda (TVP) o la embolización pulmonar, salvo en casos excepcionales en los que la tromboflebitis se extiende hacia la gran vena safena en la parte superior del muslo medial. La gran vena safena es una de las principales venas superficiales de las piernas, y cuando la tromboflebitis afecta esta estructura, existe un riesgo mayor de que el trombo pueda migrar hacia las venas profundas, lo que aumenta el riesgo de formación de un trombo en las venas profundas o incluso de una embolia pulmonar, una complicación potencialmente grave que ocurre cuando un coágulo sanguíneo viaja a los pulmones.
Varios factores predisponentes pueden contribuir al desarrollo de tromboflebitis superficial en las varices. Uno de los más comunes es el embarazo, que implica cambios hormonales y mecánicos en el cuerpo que afectan la circulación venosa. Durante el embarazo, el aumento del volumen sanguíneo y la compresión del sistema venoso por el útero pueden favorecer la formación de coágulos en las venas superficiales, particularmente en las varices. Otros factores predisponentes incluyen el trauma local, como golpes o heridas en la piel que afectan a las venas varicosas, y la inmovilidad prolongada, que puede dificultar el retorno venoso y aumentar el riesgo de formación de coágulos. Además, las personas con varices de larga evolución, especialmente en aquellas con antecedentes de insuficiencia venosa crónica, pueden ser más susceptibles a desarrollar tromboflebitis superficial.
En los pacientes mayores, las varices superficiales también pueden presentar otro riesgo significativo: el sangrado. Aunque las varices suelen ser venas dilatadas que pueden parecer frágiles, en general tienen una pared venosa más delgada y, por tanto, son más susceptibles a romperse ante un trauma, incluso de intensidad menor. Dado que la presión venosa dentro de las varices es alta debido a la disfunción de las válvulas venosas, cualquier trauma, por leve que sea, puede provocar un sangrado abundante. Este tipo de sangrado puede ser alarmante para el paciente debido a la cantidad de sangre que puede perderse, aunque en la mayoría de los casos, el sangrado se puede controlar mediante compresión local o tratamiento médico adecuado. No obstante, en situaciones donde la hemorragia es difícil de controlar, puede ser necesario un tratamiento más invasivo, como la ligadura de la vena o, en casos graves, la intervención quirúrgica.
Tratamiento
El tratamiento no quirúrgico de las varices es una opción efectiva para el manejo de la enfermedad venosa crónica, y en muchos casos puede aliviar los síntomas y prevenir la progresión de la afección sin necesidad de intervención quirúrgica. Entre las medidas no quirúrgicas más comunes se encuentran el uso de medias de compresión graduada, que desempeñan un papel crucial en la reducción de la presión venosa en las piernas. Las medias de compresión graduada, que ejercen una presión de entre 20 y 30 mm Hg, están diseñadas para mejorar el retorno venoso, aliviando la congestión sanguínea en las extremidades inferiores. Este tipo de compresión favorece la circulación sanguínea y previene la acumulación de sangre en las venas, lo que puede disminuir tanto la inflamación como los síntomas asociados con la insuficiencia venosa crónica, como la pesadez, el dolor y el edema.
El uso adecuado de las medias de compresión graduada puede ser altamente efectivo para controlar los síntomas de las varices y, en muchos casos, puede prevenir la progresión de la enfermedad venosa. Para obtener los mejores resultados, se recomienda que las medias se utilicen a diario durante las horas de vigilia, y que las piernas sean elevadas, especialmente por la noche. La elevación de las extremidades ayuda a reducir la presión venosa y facilita el retorno de la sangre al corazón. Este enfoque es particularmente útil en pacientes mayores o en aquellos que no desean someterse a cirugía. Las medias de compresión no solo son bien toleradas, sino que también son una opción menos invasiva, adecuada para aquellos pacientes que prefieren evitar procedimientos quirúrgicos.
Además de las medias de compresión, otro tratamiento no quirúrgico eficaz para las varices es la esclerosis de las venas varicosas. Este procedimiento implica la inyección directa de un agente escleroso en las venas afectadas, lo que induce una fibrosis permanente y la obliteración de la vena tratada. Los agentes esclerosos utilizados pueden ser productos químicos irritantes, como la glicerina o la solución salina hipertónica, que son particularmente efectivos para tratar venas reticulares o telangiectasias (pequeñas venas dilatadas) de menos de 4 mm de diámetro. Para venas más grandes o para la gran vena safena, así como para las venas perforantes, se utiliza la escleroterapia con espuma, que permite una mejor distribución del agente escleroso a través de las venas más grandes.
Sin embargo, la escleroterapia de las varices debe abordarse con precaución, especialmente cuando no se corrige el reflujo venoso subyacente en la gran vena safena. El reflujo en la gran vena safena es una de las principales causas de la aparición de varices, y si no se trata, el reflujo continuará dilatando las venas adyacentes incluso después de realizar la escleroterapia. Como resultado, las tasas de recurrencia de las varices pueden superar el 50%, lo que significa que el tratamiento puede no ser definitivo a menos que se aborde el reflujo subyacente. Por esta razón, es crucial que la escleroterapia de las venas varicosas se combine con una evaluación adecuada del sistema venoso profundo, para garantizar que el tratamiento sea completo y eficaz.
Al igual que con cualquier tratamiento, la escleroterapia puede presentar riesgos y complicaciones. Algunas de las complicaciones más comunes incluyen la flebitis (inflamación de la vena), necrosis tisular (muerte de los tejidos circundantes debido a la irritación química) o infección en el área de la inyección. Estas complicaciones son relativamente raras, pero deben ser consideradas al momento de decidir el tratamiento más adecuado. La experiencia del profesional que realiza el procedimiento, así como una correcta selección de los pacientes, son factores clave para minimizar estos riesgos.
El tratamiento quirúrgico para el reflujo venoso originado en la gran vena safena es una de las intervenciones más efectivas para abordar la insuficiencia venosa crónica. Este tipo de reflujo es una de las principales causas de las varices en las extremidades inferiores y se produce cuando las válvulas de la gran vena safena no funcionan correctamente, permitiendo que la sangre fluya en dirección contraria y se acumule en las venas superficiales. El tratamiento quirúrgico tiene como objetivo eliminar el reflujo venoso y mejorar la circulación al obliterar la gran vena safena, lo cual se puede lograr mediante diferentes técnicas, cada una con sus propias ventajas y consideraciones.
Uno de los procedimientos más tradicionales y efectivos para tratar el reflujo de la gran vena safena es la estrippngvenosa, una intervención quirúrgica que implica la extracción de la vena safena afectada a través de una serie de incisiones en la piel. Aunque este procedimiento es altamente efectivo a corto y largo plazo, en las últimas décadas se han desarrollado métodos menos invasivos, como los tratamientos endovenosos, que ofrecen una alternativa con menores tiempos de recuperación y una menor tasa de complicaciones.
Entre los tratamientos endovenosos más utilizados se encuentran la ablación térmica, que se realiza mediante la aplicación de energía térmica (ya sea a través de láser o de un catéter de radiofrecuencia) dentro de la vena afectada, lo que provoca su cierre y eventual reabsorción. Esta técnica se ha demostrado igualmente eficaz que el vein stripping a corto plazo, y en muchos casos, se puede realizar bajo anestesia local, lo que permite que el paciente reciba el tratamiento de manera ambulatoria. Los resultados iniciales son comparables a los del procedimiento quirúrgico convencional, con la ventaja de una recuperación más rápida y menos invasiva.
Además de la ablación térmica, existen otras opciones no quirúrgicas que se utilizan para tratar el reflujo venoso, como la inyección de cianoacrilato (un tipo de pegamento médico) y la inyección de escleroterapia con espuma. El cianoacrilatoactúa sellando la vena afectada, provocando su cierre y posterior reabsorción por el cuerpo. Esta técnica es prometedora y se está utilizando con éxito en algunos casos, especialmente en aquellos pacientes que buscan evitar la cirugía convencional. Sin embargo, la durabilidad a largo plazo de estos tratamientos, en particular el cianoacrilato y la escleroterapia con espuma, aún no está completamente establecida y requiere más estudios para evaluar su efectividad en el largo plazo.
En cuanto a la ablación térmica, uno de los principales riesgos asociados con el tratamiento es la trombosis venosa profunda inducida por el calor, un fenómeno conocido como trombosis endotérmica. Esta complicación se produce cuando el calor aplicado durante la ablación afecta a las venas profundas cercanas, provocando la formación de coágulos sanguíneos en estas venas. Aunque este tipo de trombosis es raro, en algunos casos puede ser lo suficientemente grave como para requerir anticoagulación prolongada para prevenir complicaciones más serias, como la embolia pulmonar. Por lo tanto, es fundamental que los procedimientos térmicos sean realizados por profesionales experimentados y en condiciones controladas para minimizar el riesgo de esta complicación.
Si bien la gran vena safena es la fuente más común de reflujo, también existen otras venas que pueden estar involucradas en el proceso, como la pequeña vena safena, que se encuentra en la parte posterior de la pantorrilla, o las venas perforantes, que son venas que comunican el sistema venoso superficial con el profundo. El tratamiento quirúrgico de estas venas, cuando son la causa del reflujo, se realiza generalmente al mismo tiempo que la excisión de las varices sintomáticas, de modo que se aborden todas las fuentes de insuficiencia venosa en una única intervención.
En algunos casos, el reflujo venoso superficial puede estar asociado con un reflujo venoso profundo secundario a sobrecarga de volumen, lo que significa que las venas profundas pueden mostrar signos de insuficiencia venosa debido a la presión aumentada generada por el reflujo en las venas superficiales. Cuando se corrige el reflujo en las venas superficiales, esta sobrecarga de volumen en el sistema venoso profundo puede resolverse espontáneamente, lo que mejora el retorno venoso y alivia los síntomas asociados con la insuficiencia venosa.
Pronóstico
El tratamiento quirúrgico del reflujo de las venas superficiales y la extirpación de las venas varicosas ofrecen resultados excelentes debido a la eficacia de estas intervenciones en la corrección de las alteraciones subyacentes que originan el problema, como el reflujo venoso y la dilatación patológica de las venas. El reflujo venoso superficial, comúnmente causado por insuficiencia de las válvulas venosas, provoca una acumulación de sangre en las venas, lo que lleva a la distensión y formación de venas varicosas. El objetivo del tratamiento quirúrgico es restaurar la función normal de las venas y prevenir la progresión de la patología.
El tratamiento quirúrgico adecuado puede implicar diversas técnicas, entre ellas la ligadura y extirpación de las venas varicosas (flebectomía) y la corrección del reflujo venoso a través de procedimientos como la ablación endovenosa o la fleboesclerosis. Estos enfoques son eficaces porque abordan tanto el daño mecánico de las venas como el flujo sanguíneo anómalo, eliminando o cerrando las venas afectadas y restaurando la circulación en el sistema venoso superficial. Al eliminar las venas dilatadas y corregir el reflujo, se reduce significativamente el riesgo de recurrencia de las venas varicosas y de la sintomatología asociada, como el dolor, la pesadez o la inflamación.
El alto índice de éxito del tratamiento quirúrgico, con tasas de éxito a los cinco años que oscilan entre el 85% y el 90%, se debe a la corrección duradera del reflujo y la eliminación de las venas varicosas, lo que previene la reaparición de los síntomas y la formación de nuevas varices en la mayoría de los pacientes. Esto contrasta con tratamientos más simples, como la flebectomía aislada o la esclerosis con inyecciones, que no corrigen el reflujo subyacente. Estos tratamientos, al enfocarse únicamente en la eliminación de las venas visibles, dejan intactas las causas fundamentales del problema, lo que resulta en tasas de recurrencia superiores al 50%. La persistencia del reflujo en el sistema venoso superficial, sin ser tratado adecuadamente, permite que las venas vuelvan a dilatarse con el tiempo, lo que conlleva la reaparición de las varices y los síntomas.
Sin embargo, incluso con un tratamiento quirúrgico adecuado, pueden persistir cambios tisulares secundarios, como fibrosis o alteraciones en la piel y en los tejidos subyacentes. Estos cambios son el resultado de la congestión crónica de sangre en las venas afectadas antes de la intervención, que puede causar daños en la piel y en los tejidos profundos. Aunque la corrección del reflujo y la eliminación de las venas varicosas disminuyen significativamente los síntomas y previenen la progresión de la enfermedad, las alteraciones tisulares previas al tratamiento pueden no revertirse completamente, y algunos pacientes pueden experimentar efectos residuales como hiperpigmentación o cambios en la textura de la piel. Estos efectos son más comunes en casos de insuficiencia venosa crónica grave o cuando el tratamiento se retrasa.

Fuente y lecturas recomendadas:
- Gloviczki P et al. The 2023 Society for Vascular Surgery, American Venous Forum, and American Vein and Lymphatic Society clinical practice guidelines for the management of varicose veins of the lower extremities. Part II: Endorsed by the Society of Interventional Radiology and the Society for Vascular Medicine. J Vasc Surg Venous Lymphat Disord. 2024;12:101670. [PMID: 37652254]